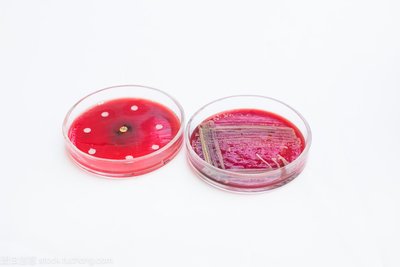

细菌是怎么耐药的?
从最早的青霉素被发现到现在,现代医学通过抗生素已经成功拯救了无数的生命。可是凡事有度,当超过这个度的时候就会产生新的问题,现在的主要问题是,新药的研发速度已经快赶不上耐药菌出现的速度了!细菌出现很多的耐药情况,这到底是怎么一回事!

一.细菌为什么会耐药?
细菌也要遵循“自然选择,优胜劣汰”的规则,适应环境的细菌就能存活、繁衍,不适应的就被淘汰。在没有抗生素的时候,环境是比较适合它们生长的,甭管高矮胖瘦都一样活着。而耐药菌在自然群体中的比例非常低,它们在繁殖上不具有优势。但如果人体内出现了抗生素,细菌生存的环境就发生了剧变,适应新环境的耐药菌更容易活下来了,就好比冰河时期突然到来,不怕冷的更容易幸存一个道理,这种“自然”选择就会推动细菌群体向着耐药性提升的方向发展。滥用抗生素有筛选耐药菌的副作用,使它们的比例上升。不断地重复使用同一种抗生素,就加强了这种筛选,体内耐这种药的菌比例越来越高,下一次生病的时候,吃这种抗生素就没用了,只好换另一种抗生素来吃,如此一来细菌又演化出对新抗生素的耐药性。

二.细菌是如何获得耐药性的
抗生素必须先与细菌的特定部位结合,然后破坏细菌的细胞结构或阻碍正常的生理功能,从而杀死或抑制细菌的生长和繁殖。针对这一过程,耐药菌有多种应对方式。
1.直接“攻击”药物,通过产生具有生物活性的酶类物质,使原有的药物结构在抗生素与细菌接触前被破坏并失效。
2. “改头换面”,通过改变抗生素与身体结合的特定部位的形状,防止抗生素与身体结合。
3.通过新陈代谢,细胞中某些物质的产量大大增加,从而抵抗抗生素的作用。
4.“关门”,通过改变细胞膜的通透性,抗生素不能进入细菌。
5. “驱逐”抗生素,建立外排系统,驱逐进入体内的抗生素,让抗生素没有发挥作用的机会。
6.“强化防御”,通过分泌一种叫做胞外多糖到白的复合物质,将自身包裹起来形成膜,不仅可以减少细菌与抗生素的接触,还可以吸附更多的生。活性酶,增强抗生素的水解破坏作用。此外,在这种膜中的细菌的代谢能力会降低,这使得细菌对抗生素不太敏感。
三.怎样使抗菌药物既能杀灭细菌,而又不让病菌产生抗药性呢?
必需根据药物性质、使用范围、用量和用法,合理应用抗生素。如果有细菌培养和药敏结果,应当根据药敏结果选择用药,而且剂量要足够,疗程要适当。要遵医嘱,不可私自购买使用或擅自停药,可有计划地将抗菌药物分期分批地交替使用,也可联合使用两种以上药物,来防止耐药菌的产生。
上一篇: 可以治好的白血病,得早发现才行
下一篇: 关于HCG你知道多少




























 版权所有© 国药东风总医院
版权所有© 国药东风总医院  鄂公网安备 42030302000164号
鄂公网安备 42030302000164号